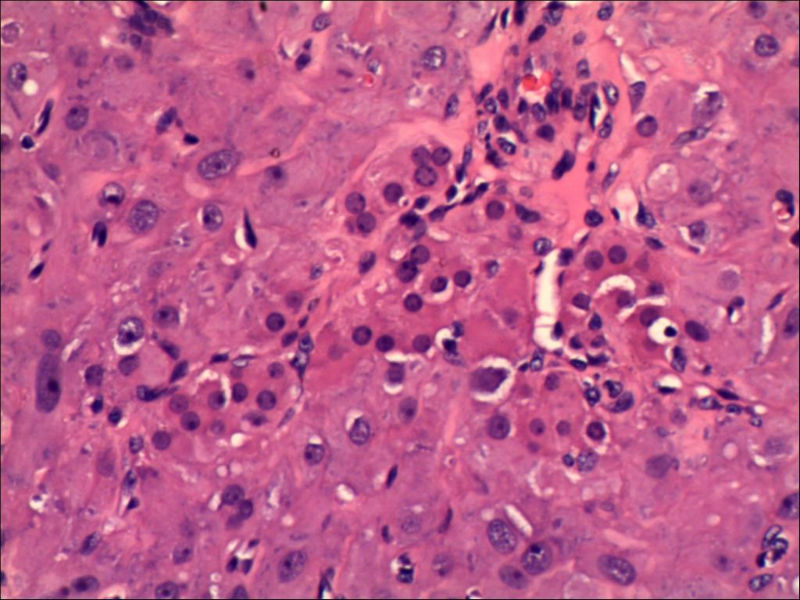
卵巢肿物图21

| 图片: | |
|---|---|
| 名称: | |
| 描述: | |
- 卵巢肿物
女,27岁,送检右侧卵巢肿物(另外还送检左侧卵巢肿物,大体及镜下显示为畸胎瘤),卵圆形,大小2×1×1cm,似有包膜。
名称:图1
描述:10503002
描述:10503002

名称:图2
描述:10503003

名称:图3
描述:10503004

名称:图4
描述:10503005

名称:图5
描述:10503006

名称:图7
描述:10503008

名称:图8
描述:10503009

名称:图9
描述:10503010

名称:图10
描述:10503012

名称:图11
描述:10503013

名称:图12
描述:10503014

名称:图13
描述:10503015

名称:图14
描述:10503016

名称:图15
描述:10503017

名称:图16
描述:10503018

名称:图17
描述:10503020

名称:图18
描述:10503021

名称:图19
描述:10503022

名称:图20
描述:10503023

名称:图21
描述:10503024
名称:图22
描述:10503025

名称:图23
描述:10503026

名称:图24
描述:10503027

名称:图25
描述:10503028

名称:图26
描述:10503029

名称:图27
描述:10503030

名称:图28
描述:10503031
标签:

- 稳扎稳打,稳中求胜
×参考诊断






















